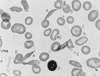

sickle cell anemia
hereditary disease that destroys red blood cells by causing them to take on a rigid “sickle” shape. The disease is characterized by many of the symptoms of chronic anemia (fatigue, pale skin, and shortness of breath) as well as susceptibility to infection, jaundice and other eye problems, delayed growth, and episodic crises of severe pain in the abdomen, bones, or muscles. Sickle cell anemia occurs mainly in persons of African descent. The disease also occurs in persons of the Middle East, the Mediterranean, and India.
Sickle cell anemia is caused by a variant type of hemoglobin, the protein in red blood cells that carries oxygen to the tissues of the body, called hemoglobin S (Hb S). Hb S is sensitive to deficiency of oxygen. When the carrier red blood cells release their oxygen to the tissues and the oxygen concentration within those cells is reduced, Hb S, in contrast to normal hemoglobin (Hb A), becomes stacked within the red cells in filaments that twist into helical rods. These rods then cluster into parallel bundles that distort and elongate the cells, causing them to become rigid and assume a sickle shape. This phenomenon is to some extent reversible after the cells become oxygenated once more, but repeated sickling ultimately results in irreversible distortion of the red cells. The sickle-shaped cells become clogged in small blood vessels, causing obstruction of the microcirculation, which in turn results in damage to and destruction of various tissues.
Sickle cell anemia is caused by the inheritance of a variant hemoglobin (Hb S) gene from both parents. (This inheritance of variant genes from both parents is known as the homozygous state.) A person who inherits the sickle cell gene from one parent and a normal hemoglobin gene (Hb A) from the other parent (an inheritance known as the heterozygous state) is a carrier of the sickle cell trait. Because the red blood cells of heterozygous persons contain both Hb A and Hb S, such cells require much greater deoxygenation to produce sickling than do those of persons with sickle cell anemia. The great majority of persons with the sickle cell trait thus have no symptoms of disease, although certain manifestations—mainly associated with vigorous exertion at high altitudes—have been seen. The overall mortality rate of persons with the sickle cell trait is no different from that of a normal comparable population.
An estimated 1 in 12 blacks worldwide carries the sickle cell trait, while about 1 in 400 has sickle cell anemia. If both parents have the sickle cell trait, the chances are 1 in 4 that a child born to them will develop sickle cell anemia. However, through amniocentesis (analysis of amniotic fluid surrounding a fetus), a testing procedure done in the early stages of pregnancy, it is possible to detect sickle cell anemia in the fetus.
The Hb S gene is distributed geographically in a broad equatorial belt in Africa and also is found, though less often, in other parts of the continent and in the Americas. The persistence of Hb S has been explained by the fact that heterozygous persons are resistant to malaria. When the red cells of a person with the sickle cell trait are invaded by the malarial parasite, the red cells adhere to blood vessel walls, become deoxygenated, assume the sickle shape, and then are destroyed, the parasite being destroyed with them.
There is no cure for sickle cell anemia; most care is devoted to alleviating symptoms. Infants and young children with the disease are given regular daily doses of penicillin to prevent serious infection. In some cases blood transfusions are given regularly to prevent organ damage and stroke and to relieve the worst symptoms of red blood cell loss. In severe cases bone marrow transplantation has been of some benefit. The drug hydroxyurea reduces the principal symptoms of sickle cell anemia. Hydroxyurea apparently activates a gene that triggers the body's production of fetal hemoglobin. This type of hemoglobin, which is ordinarily produced in large amounts only by infants shortly before and after birth, does not sickle. Hydroxyurea therapy increases the proportion of fetal hemoglobin in the bloodstream of adult patients from 1 to about 20 percent, a proportion high enough to lessen markedly the circulatory problems that arise during crises.
See also hemoglobinopathy.
Copyright © 1994-2005 Encyclopædia Britannica, Inc.